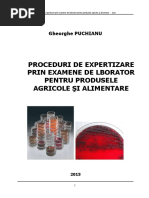

1.
2.
3.
4.
5.
6.
7.
8.
9.
10.
11.
12.
13.
14.
15.
16.
17.
18.
19.
20.
21.
22.
23.
24.
25.
26.
27.
28.
29.
30.
31.
32.
33.
34.
35.
36.
Nevoile umane sunt nelimitate ca numar si regenerabile .
Nevoile umane sunt limitate in capacitatea de consum.
Prin resurse economice ce intelege resurse naturale , uname si informationale.
Resursele economice sunt rare.
Consedinte ale legii raritatii in economie sunt eficientizarea proceselor de productie si
econimisirea resurselor .
Este considerat factor natural de productie nr mediu de zile insorite pe an.
Capitalul , ca factor de productie al unei intreprinderi , reprezinta totalitatea bunurilor
reproductibile utilizate in producerea debunuri economice.
Consecinte ale legii raritatii in economie sunt a si b.
Capitalul , ca factor de productie se prezinta sub forma tehnic si valoric.
Capitalul tehnic se prezinta sub forma fix si circulant.
Capitalul tehnic cuprinde brevetele si marcile.
Capitalul valoric include titlurile de valoare .
Capitalul fix se consuma intr-o perioada de timp ce cuprinde mai multe cicluri de productie.
Legea randamentelor neproportionale se refera la combinarea factorilor de productie .
Rezultatul combinarii factorilor de productie se apreciaza prin productivitate .
Costurile intreprinderii sunt totalitatea cheltuielilor de functionare a intreprinderilor.
Costurile de productie al intreprinderilor este expresia baneasca a consumului de factori de
productie pentru fabricarea si desfacerea produselor sale.
Este CD al unui proces de productie costul salarilor directe pe proces.
Este CD un process de productie costul materiilor prime utilizate in proces.
Este CI al unui process de productie costul amortizarii echipamentelor de productie din
intreprindere.
Este CI al unui proces de productie costul colaboratorilor de produs.
Sunt CF ale unui proces de productie cheltuielile cu amortizarea mijloacelor fixe.
Sunt CF ale unui proces de productie cheltuielile cu chiria si spatial de productie .
Sunt CF ale unui proces de productie cheltuielile independente de volumul productiei.
Sunt CV ale unui proces de productie cheltuielile care se modifica functie de volumul productie.
Sunt CV ale unui proces de analiza si control cheltuielile cu reactivii si ale material utilizate in
proces.
Sunt CV ale unui proces de productie cheltuielile cu salarile muncitorilor in acord.
Costul marginal este expresia sporului de cheltuieli la cresterea suplimentara a productiei.
Procesul de eficientizare a costurilor de productie pp reducerea costurilor si maximizarea
productiei.
Stabilirea capacitatii maxime de productie este aferenta metodei de aficientizare frontiera
posibilitatilor de productie .
Evaluarea castigului obtinut prin renuntarea la cea mai buna varianta de productie este aferenta
metodei de eficientizare costul de oportunitate.
Stabilirea volumului minim de productie este afferent metodei de aficientizare pragul de
rentabilitate.
Stabilirea volumului optim de productie este afferent metodei de eficientizare optimul de
productie .
Este un criteriu optim al producatorului minimizarea costului total de fabricatie.
Este un criteriu de optim al producatorului maximizarea profilului.
Metoda direct costing de determinare a rezultatului financiar are la baza separarea consturilor
de productie in fixe si variabile .
�37. Metoda coeficientilor de echivalenta se utilizeaza pentru omogenizarea costurilor la produsele
neomogene.
38. Metoda diviziunii simple se utilizeaza in calculul costurilor unitare la produsele omogene.
39. Monitorizarea unui indicatori strategic este obiectul pilotajului.
40. Controlul abaterilor unor indicatori fata de un model tinta este obiectul auditului.
41. Cunoasterea si valorificarea superioara a potentialului indreprinderilor este obiectul analizei
diagnostic.
42. Raportarea valorii unui indicator dependent la o variabila independent termina valoarea medie.
43. Raportarea variatiei unui indicator la variatia unei variabile independente determina valoarea
margianala.
44. Raportarea vitezei de variatie a unui indicator la variatia unei variabile independente determina
ritmul de variatie.
45. Raportarea vitezei de variatie a unui indicator la viteza de variatie a unuei variabile
independente determina elasticitatea
46. Comparatia activitatilor raportata la cea mai eficienta din inreprindere se numeste
benchmarketing intern.
47. Comparatia activitatilor la modul de manifestare al unei inreprinderi concurente se numeste
benchmarketing competitive.
48. Raportul dintre valorile aceluiasi indicator calculate in perioade diferite de timp se numeste
indice.
49. Raportul intre valorile a doi indicatori diferiti se numeste rata.
50. Exprimarea starii unui fenomen printr-o functie interogatoare de indicatori , se numeste scor
51. Metoda de diagnostic care se raporteaza la valori trecute si certe se numeste diagnostic post
factum.
52. Metoda de diagnostit care se raporteaza la valori viitoare si incerte se numeste diagnostic
previzional.
53. Metoda de analiza diagnostit care evalueaza fenomenul la un moment dat, intr o anumita
conjuctura , se numeste diagnostic static.
54. Metoda de analiza diagnostit care evalueaza fenomenul in mai multe perioade de timp, in
diverse variante de pozitionare a factorilor , se numeste diagnostic dinamic.
55. Metoda de analiza diagnostic care are ca scop determinarea evalutiei probabile a fenomenelor
si tratarea lor prin corectii la nivel global se numeste diagnostit la nivel global.
56. Este un criteriu de evaluare a cresterii economice in analizele diagnostit cifra de afaceri.
57. Care din urmatoarele domenii de analiza nu face obiectul analizei performantelor organizatiei.
58. Nu este un criteriu de evaluare a cresterii economice in analiza de diagnostic rezultatul
59. NU este un criteriu de avaluare a rentabilitatii in analizele diagnostic solvabilitatea
60. Este un criteriu de evaluare a rentabilitatii in analizele diagnostic rezultatul.
61. Este un criteriu de evaluare a potentialului economic in analizele diagnostit diagnosticul
resurselor.
62. Este un criteriu de evaluare a potentialului economic in analizele diagnostit diagnosticul
fabricatiei.
63. Este un criteriu de evaluare a potentialului economic in analizele diagnostic diagnosticul
commercial.
64. Nu este un criteriu de evaluare a resurselor interne diagnosticul resurselor naturale.
65. Nu este un criteriu de evaluare a resurselor interne diagnosticul resurselor informationale.
66. Analiza resurselor tehnice cuprinde urmatoarele determinari analiza mijloacelor fixe
67. Analiza resurselor tehnice include analiza capacitatii de productie.
68. Analiza resurselor tehnice cuprinde urmatoarele determinari analiza imobilizarilor necorporale
�69. Indicatorul mijloacelor fixe la valoare neta evalueaza la un moment dat starea mijloacelor fixe.
70. Indicatorul indicele mijloacelor fixe evalueaza la un moment dat dinamica mijloacelor fixe.
71. Indicatorul beneficiu la 1000 lei mijloace fixe evalueaza la un moment dat eficienta mijloacelor
fixe.
72. Indicatorul coefficient de structura evalueaza la un moment dat structura mijloacelor fixe.
73. Nu este indicator in analiza capacitatii de productie coeficientul de uzura.
74. Este un indicator in analiza capacitatii de productie nr total de mijloace fixe.
75. Este un indicator in analiza capacitatii de productie fondul de timp lucrat.
76. Este un indicatorin analiza capacitatii de productie gradul de utilizare al capacitatii de productie.
77. Este un indicator in analiza imobilizarilor necorporale superprofitul.
78. Nu este un indicator in analiza imobilizarilor necorporale gradul de functionare.
79. Un coefficient de uzura < 50% si un grad de utilizare a capacitatii de productie > 90% sunt
appreciate in diagnosticul resurselor tehnice ca adaptare foarte buna.
80. Este un indicator cantitativ in analiza resurselor umane total personal programat.
81. Este un indicator cantitativ in analiza resurselor umane diferenta de personal.
82. Este un indicator de eficienta in analiza resurselor umane diferenta de personal.
83. NU este un indicator de eficienta in analiza resurselor umane total personal programat.
84. Este un indicator de eficienta in analiza resurselor umane in activitati comerciale valoarea
adaugata.
85. Este un indicator in analiza resurselor financiare rata indatorarii globale.
86. Este un indicator in analiza resurselor financiare rata solvabilitatii patrimoniale.
87. Este un indicator in analiza resurselor financiare capacitatea de autofinantare.
88. Este un indicator in analiza resurselor financiare excedentul brut de exploatatie.
89. Nu este un indicator al structurii si calitatii fabricatiei gradul de utilizare al capacitatilor de
productie.
90. NU este un indicator al structurii si calitatii fabricatiei productivitatea mijloacelor fixe
91. Este un indicator al starii echipamentelor in diagnosticul fabricatiei gradul de utilizare al
capacitatii de productie.
92. Este un indicator al starii echipam. in diagnosticul fabricatiei productivitatea mijloacelor fixe.
93. Este un indicator de eficienta in analiza activitatii comerciale indicele cifrei de afaceri.
94. Este un indicator de eficienta in analiza activitatilor comerciale cota de piata a produsului.
95. Nu este un indicator de eficienta in analiza activitatilor comerciale cifra de afaceri.
96. Cifra de afaceri reprezinta totalitatea veniturilor din vanzarea produselor/serviciilor.
97. Cifra de afaceri critica = nivel minim al veniturilor din vanzarea produselor/serviciilor necesar
acoperirii costurilor fixe.
98. Rata clientilor mari in cifra de afaceri reprezinta ponderea clientilor mari in realizarea cifrei de
afacere.
99. Coeficientul clientilor mari reprezinta ponderea clientilor mari in nr total de client.
100.
Indicele produselor fabricare reprezinta ponderea vanzarilor produselor fabricate in
totalul cifrei de afaceri.
101.
Prouctivitatea vanzarilor la nr de salariati se calculeaza ca raport intre cifra de afaceri si
nr mediu de salariati in anul de referinta.
102.
O crestere sistematica < 10% pe an a cifrei de afaceri, un coefficient de siguranta >2 si o
structura ideala de sortimente sunt appreciate in analiza diagnostic ca adaptare foarte buna
103.
Coeficinetul de siguranta al cifrei de afaceri reprezinta raportul dintre cifra de afaceri si
valoarea ei critica.
104.
O Descrestere sistematica >10% pe an a cifrei de afaceri , un coefficient de siguranta <1
si o structura deficitara pe sortimente ( G 1) sun appreciate ca inadaptare totala.
�105.
Valoarea adaugata reprezinta plusul realizat prin intreaga activitate economica
106.
Valoarea adaugata este expresia eficientei consumului de factori de productie.
107.
Valoarea adaugata exclude din calcul consumul atributiei tertilor.
108.
Urmatoarele categorii de costuri nu sunt luate in considerare in evaluarea structural a
valorii adaugate material.
109.
Urmatoarele categorii de costuri nu sunt luate in considerare in evaluarea structural a
valorii adaugate cu servicii executate de terti.
110.
Este considerat in calculul valorii adaugate marja comerciala
111.
Eficienta valorii adaugate se apreciaza functie de nivelul de variatie al costurilor cu
personalul.
112.
Eficienta valorii adaugate se apreciza functie de nivelu de variatie al costurilor cu
amortizarea imobilizarilor.
113.
Eficienta valorii adaugate se aprecieaza functie de nivelul de variatie al costurilor cu
capitalul investit.
114.
O descrestere sistematica cu peste 10% pe an a valorii adaugate si o eficienta in scadere
a tuturor factorilor de productie sunt appreciate in diagnostic ca inadaptare totala.
115.
O crestere sistematica cu peste 10% pe an a valorii adaugate in ultimii 3 ai si o eficienta
in crestere a tuturor factorilor de productie sunt appreciate in analiza diagnostic ca adaptare
foarte buna.
116.
Lichiditatea reprezinta capacitatea intreprinderii de [Link] onora la scadenta obligatiile de
plat ape seama activelor curente.
117.
Solvabilitatea capacitatea intreprinderii de [Link] onora in totalitatea obligatii de plata.
118.
Rata lichiditatii curente exclude din calculul activelor curente nu exclude nicio categorie
de active curente.
119.
Rata lichiditatii partiale exclude din calculul activelor curente stocurile.
120.
Rata lichiditatii imediate exclude din calculul activelor curente stocurile si creantele.
121.
Solvabilitatea generala se refera a gradul de acoperire al datoriilor totale prin activele
totale.
122.
Solvabilitatea patrimoniala evalueaza gradul de acoperire al capitalului mobilizat prin
capitalul propriu.
123.
Rentabilitatea unei intreprinderi se apreciaza prin rezultate si efecienta utilizarii
factorilor de productie.
124.
Rezultatul optional este indicator al rentabilitatii activitatii de productie.
125.
Rezultatul de exploatare este indicator al rentabilitatii activitatilor de productie si
comercializare.
126.
Rezultatul brut este indicator al rentabilitatii tuturor activitatilor
127.
Rezultatul net este indicator al rentabilitatii patrimoniale.
128.
Rata rentabilitatii comericiale este un indicator al rentabilitatii vanzarilor.
129.
Rata rentabilitatii ec este un indicator al rentabilitatii utilizarii activelor.
130.
Rata rentabilitatii financiare este un indicator al rentabilitatii utilizarii capitalurilor.
131.
Bratul parghiei financiare este un indicator al rentabilitatii utilizarii capitalurilor proprii.
132.
Descresterea sistematica cu peste 10% pe an sau valori actuale<1% ale rentabilitatii
comerciale sunt appreciate in analiza de diagnostic ca inadaptare totala.
133.
O crestere sistematica cu peste 10% sau valori actuale >20% ale rentabilitatii comerciale
sunt appreciate in analiza diagnosic ca adaptare foarte buna.
134.
O crestere sistematica cu peste 10% sau valori actuale > 40% ale rentabilitatii ec sunt
appreciate in analiza diagnostic ca adaptate foarte buna.
�135.
In anul 2010 cifra de afaceri a fost de 250.000 iar in 2011, 280.000. Indicele cifrei de
afacere este 1,12.
136.
Daca consecintele neindeplinirii unui criteriu sunt extreme de grave la nivel de
intreprindere, in analiza diagnostic criteriul este apreciat ca foarte important.
137.
Daca consecintele neindeplinirii criteriului sunt grave cu effect sectorial, in analiza
diagnostic criteriul este apreciat ca major.
138.
Daca consecintele neindeplinirii criteriului sunt izolate la nivel compartimental, in
analiza diagnostic criteriul este aprecial ca secundar.
139.
Recomandari privind renuntarea la process sau externalizarea lui sunt date in analizele
fiagnostic in situatie de inadaptare totala.
140.
Recomandarile prvind restructurarea importanta a proceselor, controlul cheltuielilor si
inectii de capital sunt date de analizele diagnostic in situatia adaptare la limita.
141.
O intreprindere realizeaza in 2011 produse in valoarea adaugata de 200.000 cu cheltuieli
cu material de 120.000 , cu personalul60.000 si financiare 5000. Rata cheltuielilor cu personalul
la valoare adaugata este 30%.
142.
O intreprindere realizeaza in 2011 produse in valoarea adaugata de 200.000 cu cheltuieli
cu material de 120.000 , cu personalul60.000 si financiare 5000. Rata medie a cheltuielilor cu
valoare adaugata este 60%.
143.
O intreprindere detine active circulante in valoare totala de 2500, stocuri 1500, creante
800 in timp ce datoriile pe termen scurt sunt 2000. Rata lichiditatii curente 1.25.
144.
O intreprindere detine active circulante in valoare totala de 2500, stocuri 1500, creante
800 in timp ce datoriile pe termen scurt sunt 2000. Rata lichiditatii partiale este 0.5.
145.
O intreprindere detine active circulante in valoare totala de 2500, stocuri 1500, creante
800 in timp ce datoriile pe termen scurt sunt 2000. Rata lichiditatii immediate 0.1
146.
O intreprindere realizeaza in 2011 produse in valoarea adaugata de 200.000 cu cheltuieli
cu material de 120.000 , cu personalul60.000 si financiare 5000. Rata cheltuielilor cu personalul
la valoare adaugata este 30%
147.
O intreprindere realizeaza in 2011 produse in valoarea adaugata de 200.000 cu cheltuieli
cu material de 120.000 , cu personalul60.000 si financiare 5000. Rata cheltuielilor financiare la
valoare adaugate este 2.5%.
148.
O intreprindere detine active circulante in valoare totala de 2500, stocuri 1500, creante
800 in timp ce datoriile pe termen scurt sunt 2000. Rata lichiditatii curente este 1.25
149.
O intreprindere detine active circulante in valoare totala de 2500, stocuri 1500, creante
800 in timp ce datoriile pe termen scurt sunt [Link] lichiditatii partiale este 0.5
150.
O intreprindere detine active circulante in valoare totala de 2500, stocuri 1500, creante
800 in timp ce datoriile pe termen scurt sunt 2000. Rata lichiditatii immediate este 0.1
151.
Pretul unui produs este 100 lei. CF 4000lei, CVu 50. Volumul productiei vandute la care
profitul este zero ( prag de rentabilitate) este 80
152.
M.prime2000, energie500,salarii in regie1000, salarii in acord500,amortizari [Link] 500.
153.
400buc A, [Link] se diferentiaza prin timpul de fabricatie care este dublu pt
[Link] echivalenta de produse realizate in process,raportata la A este 700.
154.
O intreprindere cumpara active imobilizate in valoare totala de 24.000 amortizari in 5
ani. Valoarea neta a activelor dupa 2 luni de achizitie este 20000.
155.
O intreprindere detine active imobilizate in valoare totala de 24.000 lei pentru care la un
moment dat, amortizarea 6000lei. Coeficientul de depreciere 10%.
156.
Un process de fabricatie utilizeaza 15 salariati,3 auxiliari,2 [Link]
personalului direct productive este 67%
�157.
Un process de fabricatie realizeaza profit din exploatarea 5000lei in conditiile in care
cosryrile cu amortizarea imobilizarilor sunt 500. Excedentul brut de exploatare este 5000.
158.
Un proces de fabricatie realizeaza profit de exploatare 5000 lei si pierdere financiara
500lei. In conditiile in care costurile lunare cu amortizarea imobilizarilor sunt 500lei si cota de
impozit pe profit 16%capacitatea de autofinantare este 4200
159.
Produsul a 400g, B 250g. Costul lunar al m. prime este 1300. COstul lunar de m. prima
aferenta produsului Autilizan procedeul suplimentarii in forma clasica este 500.
160.
Produsul A 500 buc, B 300 buc. COstul total al salariilor 3200, costul unitary, utilizand
diviziunea simpla 4.
161.
Pretul unui produs este de 100um/buc. CF de fabricatie sunt 4000 um,iar CV pe initatea
de produs sunt 50um. Volumul productiei vandute la care profitul este 1000 lei este 100.
162.
Un proce de fabricatie realizeaza cate 500 buc din 2 produse , neomogene dpvd al
timpului de realizare, astefel produsul A-30 minute si produsul B 45 minute. In conditiile in care
costul lunar cu utilitatile este 1250 lei, costul unitary afferent produsului a , prin meroda
coeficientilor de echivalenta este 1.
163.
O intreprindere a avut in trecut 10 salariati, 6 muncitori,2tehnicieni , 1 econimist si un
director, cu salariile tarifare de 1200 lei,1600,2000,[Link] tarifar mediu a fost in aceasta
perioada 1540.
164.
O intreprindere a vandut in anul 2010 produse cu pretul mediu de 20 lei,iar in 2011 cu
10% mai mare . Indicele preturilor este 110.
165.
O intreprindere cumpara in luna decembrie 2010 o masina de transport in valoare de
60000. Care este valoarea neta a masinii la sfarsitul exercitiului financiar 2012 daca durata de
viata estimate este de 5 ani. 48000